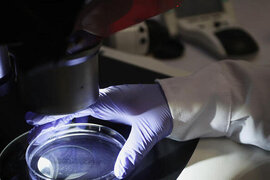
.

Xəbərlər
Uşağın göbəyinin kəsilməsi mütləq lazımdırmı?
Adətən uşaq doğulduqdan bir-neçə dəqiqə sonra onun göbəyini kəsirlər. Amma, son zamanlar bəzi həkimlər doğuşdan sonra körpənin göbəyini kəsmirlər, onun özü-özünə qopub ayrılmasını gözləyirlər. Bu üsul təbii sayılır və an
Mədə qazı necə keçər?
İnsanlar bəzən çox yeməkdən və ya soyuqlamadan mədə qazları yaşayırlar. Mədə qazı vücudda şiddətli ağrılar və şişkinlik hissi yaradır. Mədə qazı necə keçər?. Mədə qazı həzm sistemi ilə onikibarmaq bağırsağına qədər olan qismind
Xərçəng xəstəliyi haqqında
Əgər xərçəng erkən mərhələdə aşkar edilərsə onu müalicə etmək mümkündür. Önəmli olan orqanizmə diqqət etməkdir, onun hansı vəziyyətdə özünü yaxşı hiss etməsi və nə zaman sapmasını anlamaq lazımdır. İnsan onkologiya xəstəliyin
Şəkər xəstəliyinin ilkin əlamətləri
Bəzən insanlarda şəkər xəstəliyi olur, amma onlar bundan xəbərsiz yaşayırlar. Xəstəlik ağırlaşmalarla üzə çıxanda isə artıq iş-işdən keçmiş olur. Bəs şəkər xəstəliyinin ilkin əlamətləri hansılardır?. * yorğunlaq. * halsızlıq
ABŞ 100 üçün 500 milyon doza "Pfizer" peyvəndi alacaq
Ağ Ev "Pfizer" və "BioNTech" şirkətləri ilə digər ölkələrə yardım məqsədilə hazırlıdıqları 500 milyon doza koronavirusa qarşı peyvəndini almaq üçün müqavilə imzalayıb. Trend-ə istinadən bildirir ki, b

Stress zamanı nə etmək lazımdır?
Qorxu, qəzəb, vicdan əzabı. Bu hissləri hamımız keçirmişik. Psixoloqlar belə anlarda insanın sinir sisteminin gərginləşdiyini qeyd edirlər. Bu zaman isə insanlarda ürəkdöyünmə, istilikbasma, titrətmə, qıcıqlanma hissi olur

Boğazda quruluq nəyin əlaməti sayılır?
Terapevtlər boğazda quruluğun müxəlif xəstəliklər səbəbindən əmələ gəldiyini deyirlər. Onların sözlərinə görə bu adi infeksiya xəstəliyindən tutmuş, ağır xəstəliklərin belə patoloji əlaməti hesab edilə bilər. Dizqnozu mütlə

Əgər başınız ağrıyırsa MÜTLƏQ OXUYUN
Baş ağrıları hər birimizi vaxtaşırı narahat edir. Lakin bilmək vacibdir ki, baş ağrıları müxtəlif cür olur və fərqli səbəblərdən dolayı yaranır. Bəs adi yorğunluq ilə orqanizmin həyəcanlı siqnalını necə fərqləndirmək olar?

Pudra necə hazırlanır?
Pudra kosmetik vasitədir. Qadınlar ondan kosmetik vasitə kimi istifadə edirlər. Günümüzdə mağazalarda yüzlərlə növ pudralar satılır. Bunlardan bəziləri təbii üsullarla hazırlandığına görə heç bir allergik reaksiyaya səbə

40 yaşdan yuxarı olanlar üçün kakaonun faydaları
Dadlı kakao içkisi insan orqanizminə enerji verir, onu virus və infeksiyalardan qoruyur. Səhərlər bir fincan kakao içmək əhval ruhiyyəni yüksəldir, orqanizmin həyat tonusunu artırır. Onun tərkibində yaddaşı möhkəmləndirə

Ürək çatışmazlığı nədir?
Ürək çatışmazlığı elə patoloji haldır ki, bu zaman ürəyin funksiyasının pozğunluğu onun qanı orqanizmin metobolik təlabatını təmin etmək üçün lazım olan sürətlə qovmağa qabil olmamasına gətirib çıxarır. Ürək çatışmazlığ

Ürəyin əsas funksiyaları
Ürək ritminin və keçiciriyilinin pozğunluqları avtomatizm,oyanıcıliıq,və keçicirilik funksuyalarının dəyişməsi nəticəsində meydana çıxır. AVTOMATİZM FUNKSİYASI. Xarici qıcıqların olmadığı halda ürəyin impulslarının törəmə

Depressiyanın mədə-bağırsağa təsiri
Mütəxəssislər depressiyanın insanlarda fiziki xəstəliklərə səbəb olduğunu söyləyirlər. Psixoloji xəstəliklər orqanizmdə müxtəlif xəstəliklərin əmələ gəlməsinə səbəb olur. Onların araşdırmaları gənc nəslin nümayəndələrini

Uşaqlığın fibromioması
Fibromiomalar - xoşxassəli şişlərdir. Statistikaya görə 30-50 yaşa qədər hər 10 qadından 4-də uşaqlıgın fibromiomasına rast gəlinir ki,əzələ və birləşdirici toxumada əmələ gələn təkli düyün və ya bir neçə xoş xassəli törəmələri

Dırnaqların soyulma problemi
Dırnaqların soyulması- distrofik dəyişiklik olub, dırnaq lövhəciyinin nazilməsi və qabıqlanması ilə səciyyələnir. Dırnaqların kövrəkliyi və deformasiyası ilə bərabər soyulan dırnaqlar da onixodistrofiyalara aid edilir. Dırnaqları

Xroniki depressiya
İnsanlar duyğu və düşüncələrini daima öz beynində analiz edərək onu özünün probleminə çevirərək yaşayırlar. Belə düşüncələrə ev, sosial həyat, maddi, mənəvi problemlər, sevgisizlik və s. aiddir. Hər şeyi daima düşünərək ö

Kondisionerlər koronavirusa qarşı bədənin müqavimətini zəiflədir - UZAQ DURUN
Kondisionerlərdən gələn soyuq hava nəticəsində bədənin soyuması orqanizmin virusa qarşı müdafiəsini azaldır, immuniteti zəiflədir. Eləcə də kondinsioner burun yollarını qurutduğundan, yuxarı tənəffüs yollarının selikli qişalas
Alimlər koronavirusdan sonra görünə biləcək sindromu açıqladı
Birminhem Universitetinin alimləri COVID-19-dan sağalanlarda təhlükəli kəskin autoimmun iltihab sindromunun inkişaf edə biləcəyini söyləyib. Tədqiqat müəllifi Aleks Riçtner qeyd edib ki, koronavirusdan sonra ürək və dər

Payızda mutantlar gələcək, indiki kovid ştamlarını əvəz edəcək - Bəs nə etməli?
Payızda mutantlar gələcək, indiki kovid ştamlarını əvəz edəcək - Bəs nə etməli?. Mutantlar insanlığa sarı gəlir. Alimlər xəbərdarlıq edir. Onlar daha güclü və yoluxdurucu variantlardır. Payızda qışa doğru mutantlar indik

Koronavirusa yoluxan bu insanlar xəstələnmir - Səbəb
Alimlər ilk dəfə koronavirusa yoluxan insanların niyə xəstələnmədiyini üzə çıxaran dəlillər əldə ediblər. xəbər verir ki, britaniyalı alimlərin araşdırmasına görə, həmin asemptomatik insanlarda "HLA-DRB1*04:01"

Alüminium içki qabları təhlükəli ola bilər
Həkimlər uzun müddətdir ki, şəkərli qazlı sulardan imtina etməyə çağırır. Bu onların kifayət qədər kalorili olduğuna, şəkər və turşuların dişlərə mənfi təsirinə görədir. Üstəlik, qazlı içki həvəskarları tez-tez həzm sistem

Mobil telefonlar insan sağlamlığına zərərli radiasiya yayırmı?
Sinergiya Universitetinin İnformasiya Texnologiyaları fakültəsinin direktoru Stanislav Kosaryov smartfonların təhlükəsi barədə danışıb. Bütün müasir mobil telefonların insan sağlamlığına zərərli radiasiya yaydığı barədə geni

Artan "qara kif" təhlükəsi üçün risk qrupunda olanlar açıqlandı
Koronavirusdan sonra dünyanı indi də mukormikoz ("qara kif") xəstəliyi təhdid edir. Elm adamları Hindistanda başlayan və artıq Misir, İraq, Pakistan, Rusiya, Banqladeş hətta Braziliya kimi ölkələrdə yayılan xəstəliy

İnsanlarda xərçəng xəstəliyinin olmasını bildirən əlamətlər
Mütəxəssislər 50 yaşdan yuxarı bütün qadınların ildə bir dəfə mammoqrafiyadan keçmələrini məsləhət bilirlər. Buna səbəb isə 50 yaşdan yuxarı qadınların döş xərçənginə yaxalanma riskinin yüksək olmasıdır. Bəzi əlamətlər vardı

Uşağın cinsiyyətini Çin təqvimi ilə hesablayın! - 95% DOĞRU
Azərbaycan toylarında yengə nə üçün lazımdır?
Yuxuda sevişmək nəyə yozulur?
Cinsi əlaqə zamanı nə etmək lazımdır?
D vitamininin ziyanı üzə çıxdı
Qatıq yeməyin də saatı varmış: Faydası qat-qat artır
Mətbəxdə istifadə edilən 3 yağ xərçəngə səbəb olurmuş
Səhər və axşam fərq etmədən zəhər istehlak edirik
Şeflərin "uzaq durun" dediyi 6 şirniyyat: Sifariş vermədən əvvəl iki dəfə düşünün
Ramazandan sonra necə qidalanmaq lazımdır?
"Yaxın 10-15 ildə alimlər insan ömrünü azı 10 il uzada biləcəklər"
Guya irad bildirib, özünü ağıllı göstərməyə ehtiyac yoxdur
Efirlərdən küsmüşəm' - Aşıq Əli
Təəssüf ki, aktyorlar kölgədə qalıblar' - Əməkdar artist
Gündəlik optimal yuxu vaxtı - Alimlərin YENİ KƏŞFİ